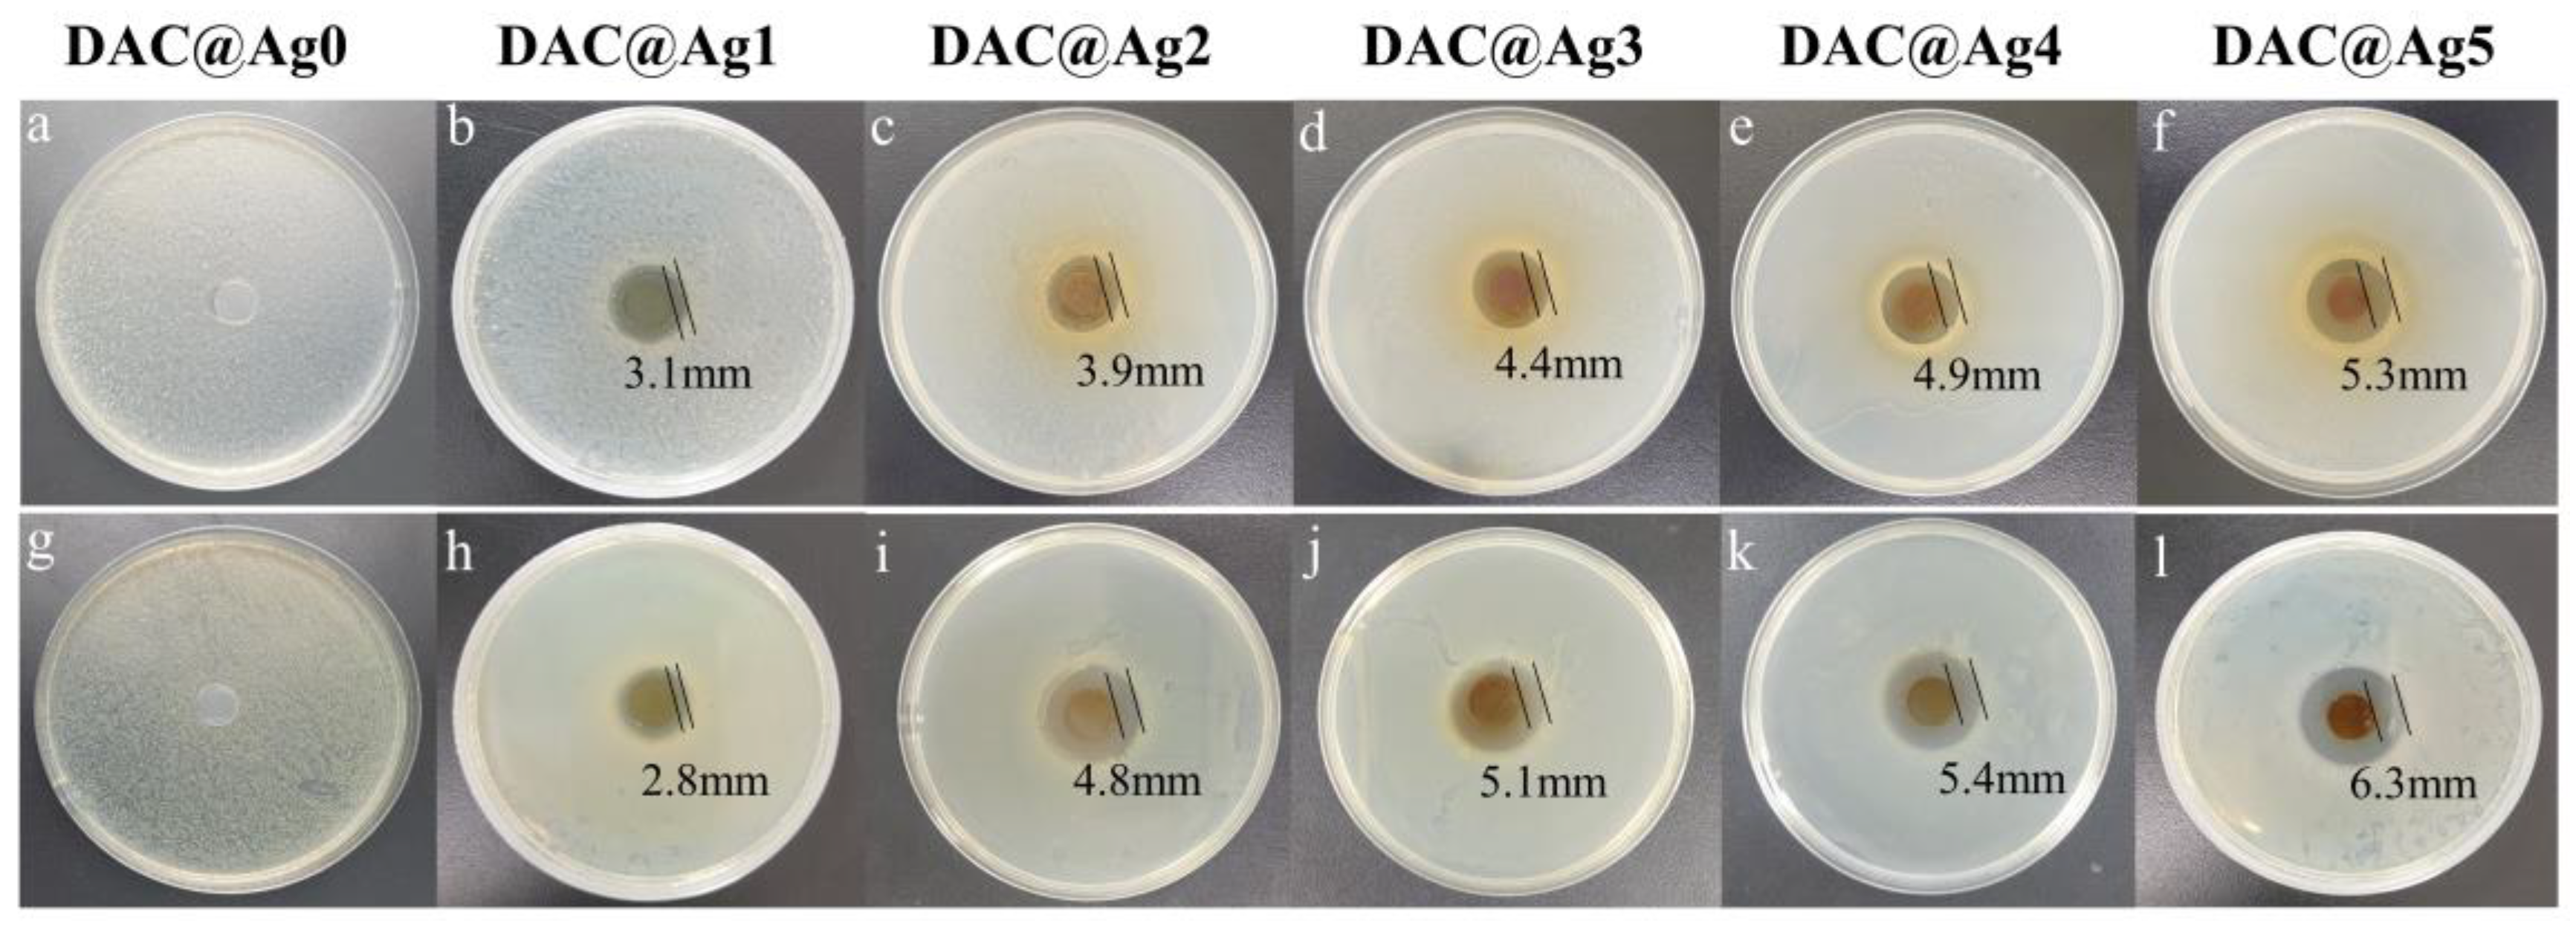
Molecules 28 02956 g009 Molecules 28 02956 g009

Dialdehyde Cellulose Solution as Reducing Agent: Preparation of Uniform Silver Nanoparticles and In Situ Synthesis of Antibacterial Composite Films with High Barrier Properties
Abstract
1. Introduction
2. Results and Discussion
2.1. Effect of Reaction Conditions on the Formation of Silver Nanoparticles
2.1.1. Different Mass Ratio of DAC to Silver Ammonia Solution
2.1.2. Different Reaction Times
2.1.3. Different Reaction Temperatures
2.1.4. Different Silver Ion Contents
2.2. Chemical Structure and Morphological Analysis
2.3. Performance Analysis of DAC@Ag Composite Films Synthesized In Situ
3. Experimental Section
3.1. Materials and Chemicals
3.2. Periodate Oxidation and Hydrothermal Dissolution of Cellulose
3.3. Preparation of AgNPs
3.4. In Situ Synthesis of DAC@Ag Composite Films
3.5. Analytical Characterization
3.5.1. Determination of DAC Oxidation
3.5.2. Analytical Characterization of Nanosilver and Cellulose
3.5.3. Analytical Characterization of the Composite Films
4. Conclusions
Supplementary Materials
Author Contributions
Funding
Institutional Review Board Statement
Informed Consent Statement
Data Availability Statement
Conflicts of Interest
References
- Lei, Y.; Mao, L.; Yao, J.; Zhu, H. Improved mechanical, antibacterial and UV barrier properties of catechol-functionalized chitosan/polyvinyl alcohol biodegradable composites for active food packaging. Carbohydr. Polym. 2021, 264, 117997. [Google Scholar] [CrossRef] [PubMed]
- Shankar, S.; Rhim, J.W. Antimicrobial wrapping paper coated with a ternary blend of carbohydrates (alginate, carboxymethyl cellulose, carrageenan) and grapefruit seed extract. Carbohydr. Polym. 2018, 196, 92–101. [Google Scholar] [CrossRef] [PubMed]
- Cutter, C.N. Microbial control by packaging: A review. Crit. Rev. Food. Sci. Nutr. 2002, 42, 151–161. [Google Scholar] [CrossRef]
- Adamczak, A.; Ozarowski, M.; Karpinski, T.M. Curcumin, a Natural Antimicrobial Agent with Strain-Specific Activity. Pharmaceuticals 2020, 13, 153. [Google Scholar] [CrossRef] [PubMed]
- Tischer, M.; Pradel, G.; Ohlsen, K.; Holzgrabe, U. Quaternary ammonium salts and their antimicrobial potential: Targets or nonspecific interactions? ChemMedChem 2012, 7, 22–31. [Google Scholar] [CrossRef]
- Simionato, I.; Domingues, F.C.; Nerin, C.; Silva, F. Encapsulation of cinnamon oil in cyclodextrin nanosponges and their potential use for antimicrobial food packaging. Food Chem. Toxicol. 2019, 132, 110647. [Google Scholar] [CrossRef]
- Ma, Z.; Garrido-Maestu, A.; Jeong, K.C. Application, mode of action, and in vivo activity of chitosan and its micro- and nanoparticles as antimicrobial agents: A review. Carbohydr. Polym. 2017, 176, 257–265. [Google Scholar] [CrossRef]
- Gharibi, R.; Kazemi, S.; Yeganeh, H.; Tafakori, V. Utilizing dextran to improve hemocompatibility of antimicrobial wound dressings with embedded quaternary ammonium salts. Int. J. Biol. Macromol. 2019, 131, 1044–1056. [Google Scholar] [CrossRef]
- Song, J.; Kang, H.; Lee, C.; Hwang, S.H.; Jang, J. Aqueous Synthesis of Silver Nanoparticle Embedded Cationic Polymer Nanofibers and Their Antibacterial Activity. ACS Appl. Mater. Interfaces 2011, 4, 460–465. [Google Scholar] [CrossRef]
- Hu, S.X.; Hsieh, Y.L. Synthesis of surface bound silver nanoparticles on cellulose fibers using lignin as multi-functional agent. Carbohydr. Polym. 2015, 131, 134–141. [Google Scholar] [CrossRef]
- Shah, S.; Din, S.U.; Khan, A.; Rehmanullah; Shah, S.A. Green Synthesis and Antioxidant Study of Silver Nanoparticles of Root Extract of Sageretia thea and Its Role in Oxidation Protection Technology. J. Polym. Environ. 2018, 26, 2323–2332. [Google Scholar] [CrossRef]
- Adel, A.M.; Al-Shemy, M.T.; Diab, M.A.; El-Sakhawy, M.; Toro, R.G.; Montanari, R.; de Caro, T.; Caschera, D. Fabrication of packaging paper sheets decorated with alginate/oxidized nanocellulose-silver nanoparticles bio-nanocomposite. Int. J. Biol. Macromol. 2021, 181, 612–620. [Google Scholar] [CrossRef]
- Soloviev, M.; Gedanken, A. Coating a stainless steel plate with silver nanoparticles by the sonochemical method. Ultrason. Sonochem. 2011, 18, 356–362. [Google Scholar] [CrossRef] [PubMed]
- Yahyaei, B.; Azizian, S.; Mohammadzadeh, A.; Pajohi-Alamoti, M. Preparation of clay/alumina and clay/alumina/Ag nanoparticle composites for chemical and bacterial treatment of waste water. Chem. Eng. J. 2014, 247, 16–24. [Google Scholar] [CrossRef]
- Sharma, V.K.; Yngard, R.A.; Lin, Y. Silver nanoparticles: Green synthesis and their antimicrobial activities. Adv. Colloid Interface Sci. 2009, 145, 83–96. [Google Scholar] [CrossRef]
- Liu, F.K.; Hsu, Y.C.; Tsai, M.H.; Chu, T.C. Using gamma-irradiation to synthesize Ag nanoparticles. Mater. Lett. 2007, 61, 2402–2405. [Google Scholar] [CrossRef]
- Arboleda, D.M.; Santillan, J.M.J.; Arce, V.B.; van Raap, M.B.F.; Muraca, D.; Fernandez, M.A.; Sanchez, R.M.T.; Schinca, D.C.; Scaffardi, L.B. A simple and “green” technique to synthesize long-term stability colloidal Ag nanoparticles: Fs laser ablation in a biocompatible aqueous medium. Mater. Charact. 2018, 140, 320–332. [Google Scholar] [CrossRef]
- Ettel, D.; Havelka, O.; Isik, S.; Silvestri, D.; Waclawek, S.; Urbanek, M.; Padil, V.V.T.; Cernik, M.; Yalcinkaya, F.; Torres-Mendieta, R. Laser-synthesized Ag/TiO nanoparticles to integrate catalytic pollutant degradation and antifouling enhancement in nanofibrous membranes for oil-water separation. Appl. Surf. Sci. 2021, 564, 150471. [Google Scholar] [CrossRef]
- Shen, Z.; Luo, Y.; Wang, Q.; Wang, X.; Sun, R. High-value utilization of lignin to synthesize Ag nanoparticles with detection capacity for Hg(2)(+). ACS Appl. Mater. Interfaces 2014, 6, 16147–16155. [Google Scholar] [CrossRef] [PubMed]
- Xu, Q.; Jin, L.; Wang, Y.; Chen, H.; Qin, M. Synthesis of silver nanoparticles using dialdehyde cellulose nanocrystal as a multi-functional agent and application to antibacterial paper. Cellulose 2018, 26, 1309–1321. [Google Scholar] [CrossRef]
- Liu, Y.; Ahmed, S.; Sameen, D.E.; Wang, Y.; Lu, R.; Dai, J.; Li, S.; Qin, W. A review of cellulose and its derivatives in biopolymer-based for food packaging application. Trends Food Sci. Technol. 2021, 112, 532–546. [Google Scholar] [CrossRef]
- Ye, Y.H.; Zhang, Y.F.; Chen, Y.; Han, X.S.; Jiang, F. Cellulose Nanofibrils Enhanced, Strong, Stretchable, Freezing-Tolerant Ionic Conductive Organohydrogel for Multi-Functional Sensors. Adv. Funct. Mater. 2020, 30, 2003430. [Google Scholar] [CrossRef]
- Wang, W.W.; Lin, J.X.; Cheng, J.Q.; Cui, Z.X.; Si, J.H.; Wang, Q.T.; Peng, X.F.; Turng, L.S. Dual super-amphiphilic modified cellulose acetate nanofiber membranes with highly efficient oil/water separation and excellent antifouling properties. J. Hazard. Mater. 2019, 385, 121582. [Google Scholar] [CrossRef]
- Ahankari, S.S.; Subhedar, A.R.; Bhadauria, S.S.; Dufresne, A. Nanocellulose in food packaging: A review. Carbohydr. Polym. 2021, 255, 117479. [Google Scholar] [CrossRef] [PubMed]
- Xiao, Y.; Rong, L.; Wang, B.; Mao, Z.; Xu, H.; Zhong, Y.; Zhang, L.; Sui, X. A light-weight and high-efficacy antibacterial nanocellulose-based sponge via covalent immobilization of gentamicin. Carbohydr. Polym. 2018, 200, 595–601. [Google Scholar] [CrossRef] [PubMed]
- Li, J.; Kang, L.; Wang, B.; Chen, K.; Tian, X.; Ge, Z.; Zeng, J.; Xu, J.; Gao, W. Controlled Release and Long-Term Antibacterial Activity of Dialdehyde Nanofibrillated Cellulose/Silver Nanoparticle Composites. ACS Sustain. Chem. Eng. 2018, 7, 1146–1158. [Google Scholar] [CrossRef]
- Lu, F.F.; Yu, H.Y.; Zhou, Y.; Yao, J.M. Spherical and rod-like dialdehyde cellulose nanocrystals by sodium periodate oxidation: Optimization with double response surface model and templates for silver nanoparticles. Express Polym. Lett. 2016, 10, 965–976. [Google Scholar] [CrossRef]
- Plappert, S.F.; Quraishi, S.; Pircher, N.; Mikkonen, K.S.; Veigel, S.; Klinger, K.M.; Potthast, A.; Rosenau, T.; Liebner, F.W. Transparent, Flexible, and Strong 2,3-Dialdehyde Cellulose Films with High Oxygen Barrier Properties. Biomacromolecules 2018, 19, 2969–2978. [Google Scholar] [CrossRef] [PubMed]
- Kim, U.-J.; Wada, M.; Kuga, S. Solubilization of dialdehyde cellulose by hot water. Carbohydr. Polym. 2004, 56, 7–10. [Google Scholar] [CrossRef]
- Xiao, G.; Wang, Y.; Zhang, H.; Zhu, Z.; Fu, S. Dialdehyde cellulose nanocrystals act as multi-role for the formation of ultra-fine gold nanoparticles with high efficiency. Int. J. Biol. Macromol. 2020, 163, 788–800. [Google Scholar] [CrossRef]
- Pal, S.; Tak, Y.K.; Song, J.M. Does the antibacterial activity of silver nanoparticles depend on the shape of the nanoparticle? A study of the Gram-negative bacterium Escherichia coli. Appl. Environ. Microbiol. 2007, 73, 1712–1720. [Google Scholar] [CrossRef]
- Baker, C.; Pradhan, A.; Pakstis, L.; Pochan, D.J.; Shah, S.I. Synthesis and antibacterial properties of silver nanoparticles. J. Nanosci. Nanotechnol. 2005, 5, 244–249. [Google Scholar] [CrossRef] [PubMed]
- Agnihotri, S.; Mukherji, S.; Mukherji, S. Size-controlled silver nanoparticles synthesized over the range 5–100 nm using the same protocol and their antibacterial efficacy. RSC Adv. 2014, 4, 3974–3983. [Google Scholar] [CrossRef]
- Kang, H.; Buchman, J.T.; Rodriguez, R.S.; Ring, H.L.; He, J.Y.; Bantz, K.C.; Haynes, C.L. Stabilization of Silver and Gold Nanoparticles: Preservation and Improvement of Plasmonic Functionalities. Chem. Rev. 2019, 119, 664–699. [Google Scholar] [CrossRef] [PubMed]
- Panda, P.K.; Kumari, P.; Patel, P.; Samal, S.K.; Mishra, S.; Tambuwala, M.M.; Dutt, A.; Hilscherova, K.; Mishra, Y.K.; Varma, R.S.; et al. Molecular nanoinformatics approach assessing the biocompatibility of biogenic silver nanoparticles with channelized intrinsic steatosis and apoptosis. Green Chem. 2022, 24, 1190–1210. [Google Scholar] [CrossRef]
- Singh, P.; Mijakovic, I. Rowan Berries: A Potential Source for Green Synthesis of Extremely Monodisperse Gold and Silver Nanoparticles and Their Antimicrobial Property. Pharmaceutics 2022, 14, 82. [Google Scholar] [CrossRef]
- Parida, D.; Simonetti, P.; Frison, R.; Bulbul, E.; Altenried, S.; Arroyo, Y.; Balogh-Michels, Z.; Caseri, W.; Ren, Q.; Hufenus, R.; et al. Polymer-assisted in-situ thermal reduction of silver precursors: A solventless route for silver nanoparticles-polymer composites. Chem. Eng. J. 2019, 389, 123983. [Google Scholar] [CrossRef]
- Raghavendra, G.M.; Jayaramudu, T.; Varaprasad, K.; Sadiku, R.; Ray, S.S.; Raju, K.M. Cellulose-polymer-Ag nanocomposite fibers for antibacterial fabrics/skin scaffolds. Carbohydr. Polym. 2013, 93, 553–560. [Google Scholar] [CrossRef]
- Harish, R.; Sivakumar, R. Effects of nanoparticle dispersion on turbulent mixed convection flows in cubical enclosure considering Brownian motion and thermophoresis. Powder Technol. 2021, 378, 303–316. [Google Scholar] [CrossRef]
- Savadekar, N.R.; Mhaske, S.T. Synthesis of nano cellulose fibers and effect on thermoplastics starch based films. Carbohydr. Polym. 2012, 89, 146–151. [Google Scholar] [CrossRef]
- Kim, U.J.; Kuga, S. Thermal decomposition of dialdehyde cellulose and its nitrogen-containing derivatives. Thermochim. Acta 2001, 369, 79–85. [Google Scholar] [CrossRef]
- Gu, B.; Jiang, Q.M.; Luo, B.C.; Liu, C.F.; Ren, J.L.; Wang, X.H.; Wang, X.Y. A sandwich-like chitosan-based antibacterial nanocomposite film with reduced graphene oxide immobilized silver nanoparticles. Carbohydr. Polym. 2021, 260, 117835. [Google Scholar] [CrossRef] [PubMed]
- Jiang, Q.; Luo, B.; Wu, Z.; Wang, X. Antibacterial composite paper with corn stalk-based carbon spheres immobilized AgNPs. Mater. Sci. Eng. C Mater. Biol. Appl. 2020, 113, 111012. [Google Scholar] [CrossRef]
- Jiang, Q.; Lin, Z.; Gu, B.; Pang, C.; Wang, X. Green synthesis and immobilization of AgNPs by lumpy corn stalk as interlayer filling material for durable antibacterial. Ind. Crop. Prod. 2020, 158, 112987. [Google Scholar] [CrossRef]
- Liang, M.; Su, R.; Huang, R.; Qi, W.; Yu, Y.; Wang, L.; He, Z. Facile in situ synthesis of silver nanoparticles on procyanidin-grafted eggshell membrane and their catalytic properties. ACS Appl. Mater. Interfaces 2014, 6, 4638–4649. [Google Scholar] [CrossRef] [PubMed]
- Zhang, P.; Shao, C.L.; Zhang, Z.Y.; Zhang, M.Y.; Mu, J.B.; Guo, Z.C.; Liu, Y.C. In situ assembly of well-dispersed Ag nanoparticles (AgNPs) on electrospun carbon nanofibers (CNFs) for catalytic reduction of 4-nitrophenol. Nanoscale 2011, 3, 3357–3363. [Google Scholar] [CrossRef]
- Pandele, A.M.; Ionita, M.; Crica, L.; Dinescu, S.; Costache, M.; Iovu, H. Synthesis, characterization, and in vitro studies of graphene oxide/chitosan-polyvinyl alcohol films. Carbohydr. Polym. 2014, 102, 813–820. [Google Scholar] [CrossRef]
- Zhai, X.S.; Zhou, S.X.; Zhang, R.; Wang, W.T.; Hou, H.X. Antimicrobial starch/poly(butylene adipate-co-terephthalate) nanocomposite films loaded with a combination of silver and zinc oxide nanoparticles for food packaging. Int. J. Biol. Macromol. 2022, 206, 298–305. [Google Scholar] [CrossRef]
- Ortega, F.; Giannuzzi, L.; Arce, V.B.; Garcia, M.A. Active composite starch films containing green synthetized silver nanoparticles. Food Hydrocoll. 2017, 70, 152–162. [Google Scholar] [CrossRef]
- Cao, W.L.; Yan, J.H.; Liu, C.; Zhang, J.; Wang, H.F.; Gao, X.H.; Yan, H.; Niu, B.L.; Li, W.F. Preparation and characterization of catechol-grafted chitosan/gelatin/ modified chitosan-AgNP blend films. Carbohydr. Polym. 2020, 247, 116643. [Google Scholar] [CrossRef]
- Fu, F.; Gu, J.; Cao, J.; Shen, R.; Liu, H.; Zhang, Y.; Liu, X.D.; Zhou, J. Reduction of Silver Ions Using an Alkaline Cellulose Dope: Straightforward Access to Ag/ZnO Decorated Cellulose Nanocomposite Film with Enhanced Antibacterial Activities. ACS Sustain. Chem. Eng. 2018, 6, 738–748. [Google Scholar] [CrossRef]
- Dai, L.; Long, Z.; Chen, J.; An, X.; Cheng, D.; Khan, A.; Ni, Y. Robust Guar Gum/Cellulose Nanofibrils Multilayer Films with Good Barrier Properties. ACS Appl. Mater. Interfaces 2017, 9, 5477–5485. [Google Scholar] [CrossRef]
- Hajji, S.; Chaker, A.; Jridi, M.; Maalej, H.; Jellouli, K.; Boufi, S.; Nasri, M. Structural analysis, and antioxidant and antibacterial properties of chitosan-poly (vinyl alcohol) biodegradable films. Environ. Sci. Pollut. Res. Int. 2016, 23, 15310–15320. [Google Scholar] [CrossRef]
- Pinto, A.M.; Cabral, J.; Tanaka, D.A.P.; Mendes, A.M.; Magalhaes, F.D. Effect of incorporation of graphene oxide and graphene nanoplatelets on mechanical and gas permeability properties of poly(lactic acid) films. Polym. Int. 2013, 62, 33–40. [Google Scholar] [CrossRef]
- Perera, K.Y.; Jaiswal, S.; Jaiswal, A.K. A review on nanomaterials and nanohybrids based bio-nanocomposites for food packaging. Food Chem. 2022, 376, 131912. [Google Scholar] [CrossRef]
- Maekawa, E.; Koshijima, T. Properties of 2, 3-dicarboxy cellulose combined with various metallic ions. J. Appl. Polym. Sci. 1984, 29, 2289–2297. [Google Scholar] [CrossRef]
- Fu, F.; Li, L.; Liu, L.; Cai, J.; Zhang, Y.; Zhou, J.; Zhang, L. Construction of cellulose based ZnO nanocomposite films with antibacterial properties through one-step coagulation. ACS Appl. Mater. Interfaces 2015, 7, 2597–2606. [Google Scholar] [CrossRef] [PubMed]
- Jiang, B.; Chen, C.J.; Liang, Z.Q.; He, S.M.; Kuang, Y.D.; Song, J.W.; Mi, R.Y.; Chen, G.G.; Jiao, M.L.; Hu, L.B. Lignin as a Wood-Inspired Binder Enabled Strong, Water Stable, and Biodegradable Paper for Plastic Replacement. Adv. Funct. Mater. 2020, 30, 1906307. [Google Scholar] [CrossRef]

| Sample | Tensile Testing | Aw (°) | Inhibition Zone (mm) | WVT (g/m2·24 h) | ORT (cm3/m2·24 h·0.1 MPa) | Water Absorption (%) | |||
|---|---|---|---|---|---|---|---|---|---|
| E (GPa) | σ (MPa) | ε (%) | E. coli | S. aureus | |||||
| DAC@Ag0 | 2.26 | 77.38 | 4.31 | 62.12 | 0 | 0 | 152.84 | <0.02 | 254.12 |
| DAC@Ag1 | 2.99 | 94.07 | 4.17 | 66.63 | 3.1 | 2.8 | 140.41 | <0.02 | 3.31 |
| DAC@Ag2 | 3.16 | 83.13 | 3.23 | 66.90 | 3.9 | 4.8 | 140.20 | <0.02 | 3.24 |
| DAC@Ag3 | 3.08 | 69.15 | 2.67 | 66.93 | 4.4 | 5.1 | 139.91 | <0.02 | 3.05 |
| DAC@Ag4 | 4.59 | 56.01 | 1.57 | 66.85 | 4.9 | 5.4 | 137.82 | <0.02 | 2.83 |
| DAC@Ag5 | 3.88 | 36.99 | 1.43 | 66.94 | 5.3 | 6.3 | 136.41 | <0.02 | 0.81 |
Disclaimer/Publisher’s Note: The statements, opinions and data contained in all publications are solely those of the individual author(s) and contributor(s) and not of MDPI and/or the editor(s). MDPI and/or the editor(s) disclaim responsibility for any injury to people or property resulting from any ideas, methods, instructions or products referred to in the content. |
© 2023 by the authors. Licensee MDPI, Basel, Switzerland. This article is an open access article distributed under the terms and conditions of the Creative Commons Attribution (CC BY) license (https://creativecommons.org/licenses/by/4.0/).
Share and Cite
Zeng, J.; Xiong, X.; Hu, F.; Li, J.; Li, P. Dialdehyde Cellulose Solution as Reducing Agent: Preparation of Uniform Silver Nanoparticles and In Situ Synthesis of Antibacterial Composite Films with High Barrier Properties. Molecules 2023, 28, 2956. https://doi.org/10.3390/molecules28072956
Zeng J, Xiong X, Hu F, Li J, Li P. Dialdehyde Cellulose Solution as Reducing Agent: Preparation of Uniform Silver Nanoparticles and In Situ Synthesis of Antibacterial Composite Films with High Barrier Properties. Molecules. 2023; 28(7):2956. https://doi.org/10.3390/molecules28072956
Chicago/Turabian StyleZeng, Jinsong, Xinyi Xiong, Fugang Hu, Jinpeng Li, and Pengfei Li. 2023. "Dialdehyde Cellulose Solution as Reducing Agent: Preparation of Uniform Silver Nanoparticles and In Situ Synthesis of Antibacterial Composite Films with High Barrier Properties" Molecules 28, no. 7: 2956. https://doi.org/10.3390/molecules28072956
APA StyleZeng, J., Xiong, X., Hu, F., Li, J., & Li, P. (2023). Dialdehyde Cellulose Solution as Reducing Agent: Preparation of Uniform Silver Nanoparticles and In Situ Synthesis of Antibacterial Composite Films with High Barrier Properties. Molecules, 28(7), 2956. https://doi.org/10.3390/molecules28072956

